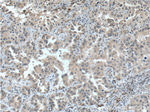
p38 MAPK Antibody in Immunohistochemistry (Paraffin) (IHC (P))

Search
Proteintech
p38 MAPK Monoclonal Antibody (1A1C2)
{{$productOrderCtrl.translations['antibody.pdp.commerceCard.promotion.promotions']}}
{{$productOrderCtrl.translations['antibody.pdp.commerceCard.promotion.viewpromo']}}
{{$productOrderCtrl.translations['antibody.pdp.commerceCard.promotion.promocode']}}: {{promo.promoCode}} {{promo.promoTitle}} {{promo.promoDescription}}. {{$productOrderCtrl.translations['antibody.pdp.commerceCard.promotion.learnmore']}}
产品信息
66234-1-IG
种属反应
已发表种属
宿主/亚型
分类
类型
克隆号
抗原
偶联物
形式
浓度
规格
纯化类型
保存液
内含物
保存条件
运输条件
产品详细信息
Immunogen sequence: MSQERPTFY RQELNKTIWE VPERYQNLSP VGSGAYGSVC AAFDTKTGLR VAVKKLSRPF QSIIHAKRTY RELRLLKHMK HENVIGLLDV FTPARSLEEF NDVYLVTHLM GADLNNIVKC QKLTDDHVQF LIYQILRGLK YIHSADIIHR DLKPSNLAVN EDCELKILDF GLARHTDDEM TGYVATRWYR APEIMLNWMH YNQTVDIWSV GCIMAELLTG RTLFPGTDHI DQLKLILRLV GTPGAELLKK ISSESARNYI QSLTQMPKMN FANVFIGANP LAVDLLEKML VLDSDKRITA AQALAHAY (1-307 aa encoded by BC031574)
靶标信息
The p38 MAPK cascade regulates a variety of cellular responses to stress, inflammation, and other signals. p38 MAPK is relatively inactive in the nonphosphorylated form and becomes rapidly activated by dual phosphorylation of a Thr-Gly-Tyr motifs. There are four isoforms of p38 MAPK, which differ in their tissue expression and affinity for upstream activators and downstream effectors. When cells are exposed to tumor necrosis factor, interleukin-1, heat shock, or other activating stimuli, activation of MAPK kinase-3 occurs by phosphorylation. Activated MAPK kinase-3/6 phosphorylate each residue of Thr180 and Tyr182 in p38 MAPK. Phospho-p38 MAPK activates ATF-2, CHOP-1, MEF-2 and other transcription factors through phosphorylation.
仅用于科研。不用于诊断过程。未经明确授权不得转售。
生物信息学
蛋白别名: CSAID-binding protein; cytokine suppressive anti-inflammatory drug binding protein; Cytokine suppressive anti-inflammatory drug-binding protein; encoded by transcript variant 4; p38 MAP kinase; encoded by transcript variant 5; p38 MAP kinase; MAP kinase 14; MAP kinase MXI2; MAP kinase p38 alpha; MAPK14; MAX-interacting protein 2; Mitogen-activated protein kinase 14; Mitogen-activated protein kinase p38 alpha; p38 MAP kinase; p38 mitogen activated protein kinase; p38alpha Exip; SAPK2a; SAPK2a; CSAIDS binding protein 1; Stress-activated protein kinase 2a; unnamed protein product
基因别名: CSBP; CSBP1; CSBP2; CSPB1; EXIP; MAPK14; MXI2; p38; p38ALPHA; PRKM14; PRKM15; RK; SAPK2A
UniProt ID: (Human) Q16539
Entrez Gene ID: (Pig) 100156630, (Human) 1432